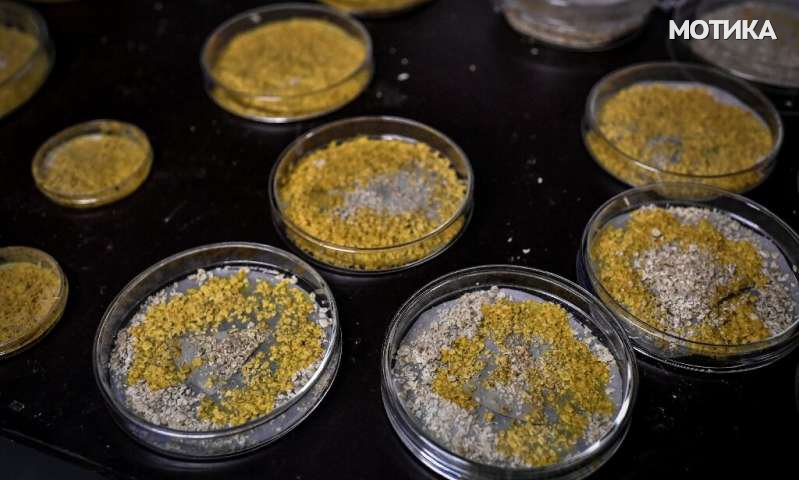

Зоолошки парк во Париз откри необичен организам кој може да лази со брзина до 4 сантиметри на час, може да ги реши проблемите и покрај тоа што нема мозок и дури може да се лекува ако се исече на два дела.
Светло жолтото суштество е наречено „блоб“ ќе се појави на изложбата во Парискиот зоолошки парк, како дел од изложбата од ваков вид, организирана да ги прикаже неговите ретки способности.
Официјално е познато како phararum polycephalum или „лига со многу глави“ и не е ниту растение, животно или габа. Блоб нема два пола како машки и женски, туку има 720. Може да се подели во различни организми, а потоа пак да се спои, според информациите објавени од Зоолошкиот парк.
Се верува дека едноклеточното суштество е старо околу милијарда години, но најпрво го привлече вниманието на јавноста уште во мај 1973 година, кога една жена од Тексас пронајде раширен жолт меур што расте во нејзината градина. Сепак блобот починал брзо колку што се појавил и повеќе никој не го истражувал сѐ до 2016 година кога едно истражување не предизвикало возбуда во научниот свет.
Студијата, објавена во списанието Proceedings of the Royal Society и со коавторка Одри Дјусутур, биолог во францускиот Национален центар за научни истражувања, покажа дека physarum polycephalum може да научи да ги игнорира штетните материи и да се сеќава на тоа однесување до една година подоцна.
Иако се вика „блоб“, тоа е нешто повеќе од тоа, бидејќи научниците веруваат дека е способен да реши проблеми, како што е пронаоѓање на најкраткиот начин за излегување од лавиринтот и предвидување на промени во неговата околина, тврдат истражувачите кои работат во Зоолошкиот парк.
Научниците го истражувале суштетсвото така што го развивале во лабораторија и го хранеле овесна каша, неговата омилена храна. Откако достигнало одредена големина, тие го префрлиле на кора од дрвја, со која суштетсвото се хранело и потоа го префрлиле во терариум, каде што посетителите сега можат да одат и да го видат во реалниот живот.
Името Блоб доаѓа од култниот хорор филм со 1958 година со истото име, во кое туѓа животна форма презема цел град во Пенсилванија.
Блоб обично може да се најде на шумските подови во Европа, при што научникот Марлен Итан објаснува: „Акакијата, дабовата кора и кората од костен му се омилени места. Тој напредува во температурите кои се движат меѓу 19 и 25 Целзиусови степени и кога нивото на влажност достигнува од 80 до 100 проценти.“